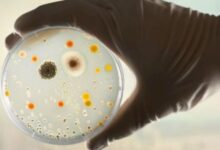

محتويات

يعيش نحل العسل ضمن مملكات كبيرة، إذ تحتوي الخلية الواحدة في المملكة على ما يُقارب 60,000 نحلة تقوم كلّ منها بوظيفة محدّدة، وتتكوّن مملكة نّحل العسل من ثلاثة أنواع من النّحل البالغ، هي: العاملات، والذّكور، والملكة.[١][٢]
تُعدُّ العاملات (بالإنجليزيّة: Workers) أصغر أفراد طائفة النّحل حجماً، وأكثرها عدداً، وهي إناث غير قادرة على التّزاوج والتكاثر في الأوضاع الطبيعية، إلّا أنّها في الحالات التي لا تتواجد فيها الملكة قد تضع بيضاً غير مخصّب ينتج عنه ذكور فقط، ويبلغ متوسط عمر العاملات خلال فصل الصيف نحو ستّة أسابيع، بينما تعيش العاملات التي تظهر في فصل الخريف فترة أطول تصل إلى ستّة أشهر، إذ تساهم في إبقاء الخلية خلال فصل الشّتاء، بالإضافة إلى تربية الجيل الجديد خلال فصل الرّبيع قبل موتها،[٢][٣] وفيما يأتي بعض من أهمّ المهام التي تؤدّيها العاملات:[٣]
- إفراز الشّمع المستخدم في الخلية، وتشكيله لبناء الأمشاط الشّمعيّة.
- جلب وجمع الرّحيق وحبوب اللّقاح من الأزهار للخلية، وتحويل الرّحيق إلى عسل.
- توفير احتياجات الملكة واليرقات، وإفراز الغذاء الملكي لإطعام الملكة واليرقات الصّغيرة.
- تنظيف الخلية من النّحل الميت.
- الدّفاع عن الخلية وحمايتها من الدخلاء.
- المحافظة على الظروف المثلى للخلية، وذلك عن طريق تهويتها وتبريدها، أو تدفئتها.
تحتوي مملكة النّحل على ملكة واحدة (بالإنجليزيّة: Queen)، وهي أنثى نتجت عن بويضة مخصّبة مثلها في ذلك مثل العاملة، إلّا أنّ الفرق بينهما يكمن في نوع الغذاء الذي تحصل عليه كلّ منهما في مرحلة اليرقة، إذ تتلقّى اليرقات التي ستتطوّر لتصبح عاملات القليل من الغذاء الملكيّ، وتتغذّى بشكلٍ رئيسي على مزيج من العسل وحبوب اللقاح، في حين تتغذّى اليرقات التي ستتطوّر لتصبح ملكة على كمية كبيرة من الغذاء الملكيّ، ويجدر بالذكر أنّ الملكة تكون ناضجة جنسياً، لذلك يمكنها التّزاوج، ووضع بيض مخصّب وآخر غير مخصّب، وقد يصل عدد البيض الذي تنتجه الملكة خلال فترة حياتها التي قد تصل إلى خمس سنوات إلى أكثر من مليون بيضة.[٢]
تتميّز الملكة عن العاملات والذكور بأنّها أكثر طولاً، كما تتّسم بجناحيها اللذين يصلان إلى ثلثيّ البطن، على عكس أجنحة باقي أفراد الخلية التي تصل إلى طرف البطن، وتختلف الملكة عن العاملات بأنّ إبرة اللّسع لديها مقوّسة وأكثر طولاً، وصدرها أكبر قليلاً، كما أنّها لا تمتلك سلالاً لجمع حبوب اللّقاح، ولا يمكنها إنتاج الشّمع، وتؤدّي الملكة بالإضافة لوضع البيض مهمّة أخرى هي إفراز الفيرمونات التي تساهم في تحديد هوية المملكة، ومن أهمّ هذه الفيرمونات المادة الملكية (بالإنجليزيّة: Queen substance) التي تنتجها غدد الفكّ السفلي، بهدف جذب ذّكور النحل للتزاوج، ومنع العاملات من تربية المزيد من الملكات.[٢][٤]
تنتج ذكور النّحل (بالإنجليزيّة: Drone) من بويضات غير مخصّبة، وتتمثّل وظيفتها الرئيسية في إخصاب الملكة العذراء، ويتميّز الذّكر برأسه الكبير مقارنةً مع العاملات والملكة، وعيونه المركّبة كبيرة الحجم التي تحيط بكامل رأسه تقريباً، وذلك ليتمكّن من رصد الملكة أثناء الطيران، ولا تمتلك ذّكور النّحل إبرة لسع، ولا سلال لجمع حبوب اللّقاح، ولا غدداً لإنتاج الشّمع، كما تعتمد في الحصول على غذائها على العاملات، ولأنّها تستهلك ثلاثة أضعاف الطّعام الذي تستهلكه العاملات؛ فإنّ الذّكور تُطرَد من الخلية مع حلول الأجواء الباردة في فصل الخريف، إلى جانب نقص موارد الغذاء من رحيق وحبوب لقاح، ومع ذلك فقد يُسمح لها بالبقاء في الخلية إذا لم يكن فيها ملكة، ومن الجدير بالذّكر أنّ الذكر الذي يتزاوج مع الملكة يموت مباشرةً بعد أداء مهمّته.[٢][٥][٦]
يوجد العديد من أنواع وسلالات نحل العسل التي تختلف فيما بينها بسبب عدّة عوامل، منها: المنطقة التي تعيش فيها، وتركيبها الجيني، وأصلها، وغير ذلك، ومن أكثرها شهرة ما يأتي:[٧]
- النّحل الإيطالي: يتميّز بألوانه الفاتحة، وبأنّه أقلّ دفاعاً عن الخليّة، وأقلّ عرضة للإصابة بالمرض مقارنة بباقي أنواع النحل، وينتج النّحل الإيطالي عسلاً ذا نوعية ممتازة، ولكن من أهمّ عيوبه أنّه قد يستهلك العسل الموجود في الخلية، كما أنّه يلجأ إلى أخذ العسل من الخلايا الضعيفة المجاورة، الأمر الذي قد يسبّب انتشار الأمراض المعديّة بين خلايا النّحل بشكل سريع.
- النّحل الألماني: هو نحل داكن اللّون، ويستطيع العيش في المناطق ذات المناخ البارد، ويتميّز بأنّه دفاعيّ للغاية عن خليته، كما أنّه عرضة للإصابة بالعديد من الأمراض.
- نحل كرينولي: يعدّ وسط أوروبا موطن نحل كرينولي الأصلي، ويتّسم هذا النوع من النحل بقدرته الكبيرة على بناء أمشاط الشّمع، كما يتميّز بأنّه مطيع وسلس للغاية، وأقلّ ميلاً لأخذ العسل من الخلايا الأخرى، بالإضافة إلى أنّه ينمو بشكل سريع في فصل الربيع، ممّا يعني زيادة أعداده، وإمكانية استفادته من الزّهور التي تتفتّح في بداية هذا الفصل.
- النّحل القوقازي: يقع موطنه الأصلي في جبال الأورال في أوروبا الشّرقية، ويتميّز النّحل القوقازي بلسانه الطّويل الذي يمكنّه من جمع رحيق الأزهار التي لا تتمكّن أنواع النّحل الأخرى من الوصول إليها، ومن عيوبه بطء عملية نموّه، ممّا يمنعه من إنتاج محاصيل عسل بكميات كبيرة، ويميل هذا النوع إلى استخدام مادة الصمغ (propolis) بشكل كبير بهدف سدّ شقوق الخلية، الأمر الذي يجعل من الصّعب التّعامل معها.
- نحل باكفاست: يتميّز بمقاومته للأجواء الرّطبة الباردة، وقدرته على إنتاج محاصيل جيدة من العسل، كما أنّه يتمتّع بالنّظافة، ممّا يقلّل من انتشار الأمراض، ويعدّ نحل باكفاست دفاعيّ بصورة معتدلة، ولكن من عيوبه أنّه لا يستفيد بشكل كامل من تدفّق الرّحيق المبكّر.
- النحّل الروسي: تعدّ منطقة أقصى شرق روسيا موطنه الأصلي، ويتميّز هذا النوع من النحل بنظافته، وتغيّر فترة نشاطه حسب أوقات وفرة الرحيق وحبوب اللقاح في بيئته، ويكون أداء النحّل الروسي أفضل عند غياب أنواع النحل الأخرى.
شاهد الفيديو لتعرف معلومات أكثر عن النّحل.[٨]
للتعرف أكثر على مملكة النحل يمكنك قراءة المقال مملكة النحل
ينتمي النّحل (بالإنجليزية: bees) لمملكة الحيوانات، وشعبة مفصليات الأرجل، وشعيبة سداسيات الأرجل، وطائفة الحشرات، ورتبة غشائيات الأجنحة، ويوجد في العالم ما يزيد عن عشرين ألف نوع من النّحل، إلّا أنّ النوع الذي ينتج العسل يشكّل نسبة تقلّ عن 4% من ذلك، أي ما يقلّ عن 800 نوع، ومن أشهرها نحل العسل الشّائع المعروف علمياً باسم (Apis mellifera)، وفي حين يعيش العديد من النّحل بصورة منعزلة أو انفرادية، إلّا أنّ نسبة الأنواع التي تعيش ضمن مجموعات تقلّ عن 8% من العدد الكلّي للنحل في العالم، كما يعيش أقلّ من 3% منها فقط داخل خلايا،[٩][١٠] ويصنّف النّحل إلى سبع فصائل، هي:[١١]
- فصيلة النحليات: (Apidae)، هي أكبر فصائل النّحل، وتضمّ أنواع نحل اجتماعيّة وأخرى انفراديّة، ومن أشهر أصناف هذه الفصيلة؛ نحل العسل، والنّحل الطّنان، والنّحل النّجار، والنّحل الحفّار، ونحل السّحلب.
- فصيلة النّحل القارض: (Megachilidae)، هي فصيلة من النّحل الانفرادي، وتتميّز بأنّها تحمل حبوب اللّقاح في الجهة السّفلية من البطن، وليس على الأرجل الخلفية كما هو حال باقي النّحل، ومن أشهر أنواعها؛ النّحل القارض للأوراق، والنّحل البنّاء.
- فصيلة نحل هاليكاليد: (Halictidae)، يبني نحل هاليكاليد خلاياه على الأرض، ويُعرف أيضاً باسم نحل العرق، وذلك لأنّ بعض الأنواع التي تنتمي إليه تنجذب للأملاح الموجودة في عرق الإنسان، وتضمّ هذه الفصيلة أنواع نحل قد تغيّر في طريقة معيشتها بين المعيشة الاجتماعيّة والانفراديّة، وذلك تبعاً للبيئة التي توجد فيها.
- فصيلة نحل أندرينيدا: (Andrenidae)، هو نحل انفرادي يبني خلاياه على الأرض، وينتمي معظم أفراد هذه الفصيلة إلى نحل المناجم من جنس اندرينا (Andrena).
- فصيلة نحل كوليتيديا: (Colletidae)، يُعرف نحل كوليتيديا أيضاً باسم نحل السيلوفان (cellophane bees)، أو نحل البوليستر (plasterer bees)؛ وذلك لأنّه يفرز مادة بلاستيكيّة بيولوجية يستخدمها لصناعة بيته وحمايته من الماء، وتضمّ هذه الفصيلة نحل (Hylaeus) الذي يتميّز بعدم وجود شعر على جسمه، بالإضافة إلى أنّه يحمل حبوب اللّقاح في معدته.
- فصيلة نحل (melittidae): هو نّحل انفرادي يبني خلاياه على الأرض، وتتميّز هذه الفصيلة عادة بحجمها الصغير أو المتوسّط، ولونها الأسود، وتضمّ عدّة أجناس منها (Hesperapis) الذي يمكن تمييز أفراده من خلال عيونهم الخضراء، وبطنهم المسطّح.
- فصيلة نحل (Stenotritidae): هي أصغر فصائل النّحل، وتعيش فقط في أستراليا، وهي عبارة عن نحل انفرادي يبني بيته على الأرض.
- ↑ “Honeybees”, www.whatsinaname.hmnh.harvard.edu, Retrieved 9-5-2020. Edited.
- ^ أ ب ت ث ج “The Colony and Its Organization”, www.agdev.anr.udel.edu, Retrieved 9-5-2020. Edited.
- ^ أ ب “About Honey Bees – Types, Races, and Anatomy “, www.uaex.edu, Retrieved 9-5-2020. Edited.
- ↑ “Queen substance”, www.britannica.com, Retrieved 9-5-2020. Edited.
- ↑ Christopher Jernigan (13-6-2017), “Colony Life of a Honey Bee”, www.askabiologist.asu.edu, Retrieved 9-5-2020. Edited.
- ↑ Debbie Hadley (28-9-2019), “How Long Does a Queen Bee Live?”، www.thoughtco.com, Retrieved 9-5-2020. Edited.
- ↑ “The Different Types of Honey Bees”, www.content.ces.ncsu.edu, Retrieved 7-5-2020. Edited.
- ↑ فيديو معلومات عن النّحل.
- ↑ “Apoidea “, www.itis.gov, Retrieved 6-5-2020. Edited.
- ↑ Heidi Lindberg (6-12-2017), “What do you really know about bees?”, www.canr.msu.edu, Retrieved 7-5-2020. Edited.
- ↑ “Bee Diversity”, www.beelab.umn.edu, Retrieved 6-5-2020. Edited.